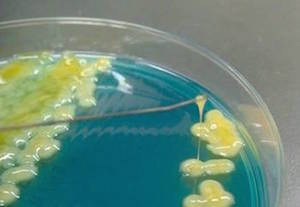
K. pneumoniae

分子疫学とゲノム解析
高病原性Klebsiella pneumoniaeの分子疫学と臨床像に関する研究
近年、通常のKlebsiella pneumoniae菌株よりも重症感染症をきたしやすい性質を持った高病原性Klebsiella pneumoniae菌株の存在が世界的に注目されている。東アジア諸国では高病原性Klebsiella pneumoniaeの分離頻度が高く、これらが健常人における市中発症の肝膿瘍や播種性感染症に関与することが報告されているが、日本における疫学はまだ十分には解明されていない。当講座では日本全国の医療機関から侵襲性感染症をきたしたKlebsiella pneumoniae菌株を収集し、これらの病原因子PCRスクリーニング、クローナリティー解析、全ゲノム解析などの分子生物学的解析結果と臨床情報を対比することにより、本邦における高病原性Klebsiella pneumoniaeの分子疫学と臨床像を明らかにすることを目指している。
過粘稠性を有する高病原性のKlebsiella pneumoniae
細菌ゲノム解析
同一種の病原菌であっても、株ごとにゲノムには特徴があり、株の病原性や薬剤感受性などと密接に関連している。DNAシーケンサー技術の発達とともにゲノム解読は容易となり、分離株の全ゲノム解析は特別なことではなくなってきた。当講座では臨床分離された菌のゲノム解析を通じて、分離菌の薬剤耐性機構の解析や分子疫学解析を行っている。さらに、日々蓄積されつつあるゲノムデータの利用法について研究を進めている。

ゲノム解析に利用するDNAシーケンサー
ORF保有パターンを利用したアウトブレイク解析
医療施設内における薬剤耐性菌のアウトブレイクは非常に問題視されており、早期介入が重要である。近年では全ゲノム解析が比較的容易に実施できるようになり、core genome SNP (cgSNP)解析による高精度なアウトブレイク解析なども可能になっている。しかし実際には、このような解析には時間とコストがかかり、医療現場での実施は難しい傾向にある。時間とコストが比較的削減可能なロングリードシーケンシングも出現したが、リードエラーが多くcgSNP解析のような精密な解析には向かないことが新たな問題点であった。
我々はロングリードシーケンシングを軸に、オープンリーディングフレーム(ORF)の保有パターンに着目することでリードエラーの問題を回避しつつ、アウトブレイク解析の迅速化および低コスト化を試みた。ORF保有パターンから作製した系統樹は従来のcgSNP系統樹と同程度のクラスタリング精度を示し、アウトブレイク解析に使用可能であることが示唆された。これにより、従来法よりも迅速かつ安価にアウトブレイク解析が可能になると考えられる。

- Hayashi K, Doi Y., Suzuki M "Rapid phylogenetic analysis using open reading frame content patterns acquired by Oxford nanopore sequencing." J Appl Microbiol., 133, 3699-3707 (2022) [PubMed]
細菌検査法の開発
細菌検査には時間がかかるものが多く、迅速化が課題である。院内アウトブレークの際に実施される分子疫学解析は従来1週間以上の時間がかかっていたが、当講座では半日程度で結果が得られる簡易な分子疫学解析法であるPCR based ORF typing法(POT法)の開発を行い、感染管理技術向上に寄与している。また、検査の迅速化を図るための基礎的な検討も進め、細菌検査技術向上に努めている。

